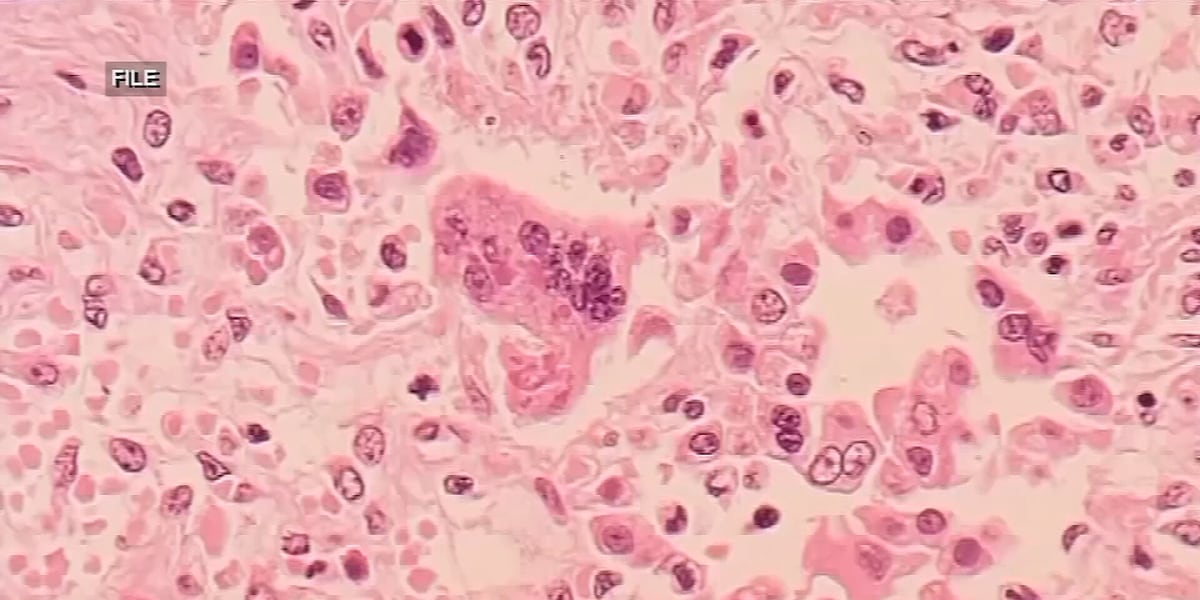

"Arizona Girl's Multiple Amputations Following Group A Streptococcus Diagnosis"
A 7-year-old Arizona girl, Victoria Pasten-Morales, has undergone multiple amputations after being diagnosed with Group A Streptococcus, with the bacterial infection affecting her lungs and kidneys. Her family is heartbroken as she fights for her life, having had eight surgeries and facing a long road to recovery. The cause of the infection is unknown, and a GoFundMe has been set up to support the family as they navigate this challenging time.